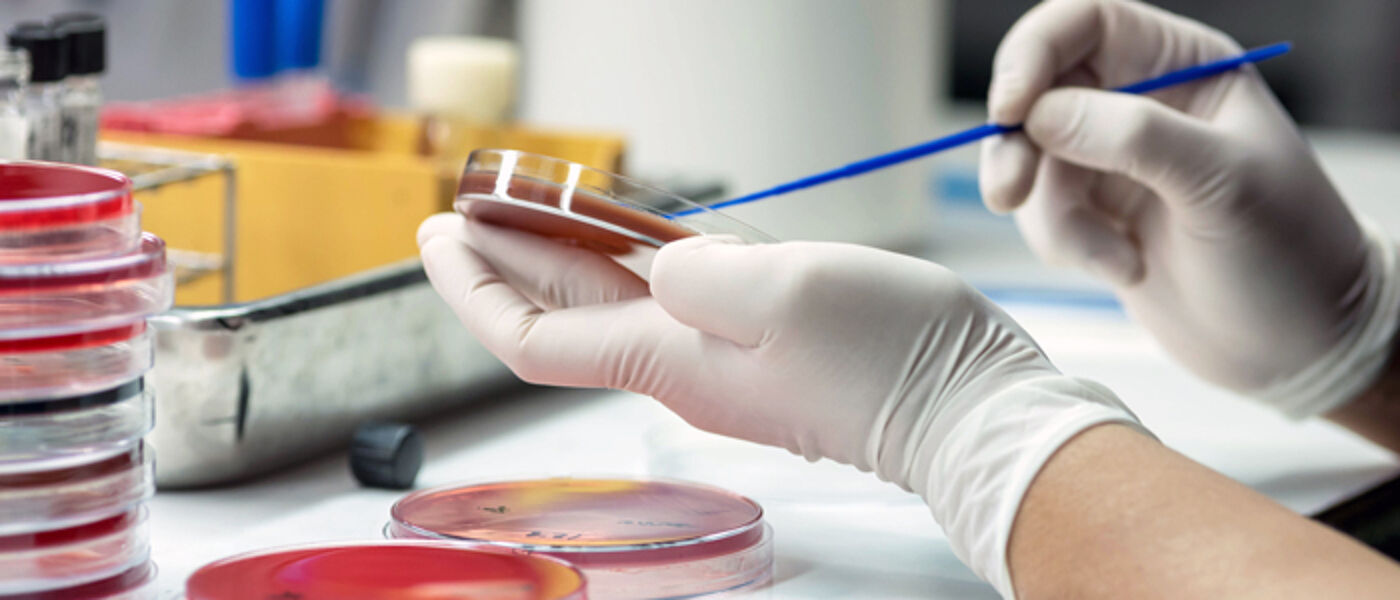
Photo of person working in lab with petri dishes

Determinants of Health and Health Inequalities
Our Determinants of Health and Health Inequalities research theme is broad and brings together a wide range of expertise and disciplines to investigate fundamental issues relating to poor health outcomes and health inequality, both locally and globally.
This work includes:
- social determinants of health
- large-scale epidemiology
- genomics
- public health
- mental health
- the health of vulnerable groups in society
- health policy
Theme leads
Dr David Blane
Senior Clinical Lecturer
General Practice and Primary Care
Dr Deborah Cairns
Professor of Health and Neurodevelopmental Conditions
Mental Health and Wellbeing